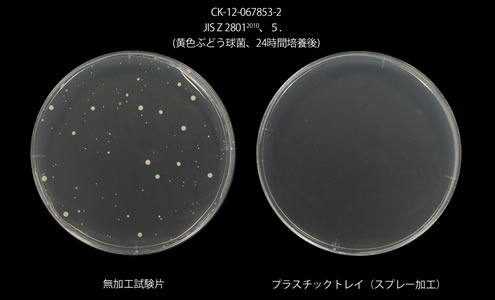

プラチナ(Pt)
プラチナは非常に安定した金属であることから、古来より装飾品などに使用され、近年では、自動車の触媒などに使用されている。酸に対して強い耐食性(抗酸化)も特徴です。
また、金属類の中でもゴールド(金)と同様に厚生労働省が食品添加物として認められており、摂取しても体内に吸収されることはありません。
ナノテクノロジー(nano)
ナノテクノロジーは近年著しい技術の進歩を遂げており、医療分野やコンピューターなどの半導体分野などに新たな可能性を持つ技術です。
プラチナナノ(Pt nano)溶液
バイオエポックは最先端のナノ技術によりプラチナナノ粒子に、クエン酸を保護剤として添加し〔抗菌〕や〔抗ウイルス〕などの
消毒効果や〔抗酸化〕効果のあるプラチナナノ(Pt nano)溶液の開発に成功しました。
プラチナナノ(Pt nano)溶液の効果及び特徴
抗菌・消臭
大腸菌・黄色ブドウ球菌・肺炎桿菌・MRSAの試験で抗菌に有効であると証明されています。
消臭も香りでニオイを隠すのではなく白金によりニオイを元から分解するので香料なども一切入っておらず無臭です。
抗ウイルス
ウイルスに対し効果を発揮。
ウイルスの侵入を防ぐだけではなく、ウイルス自体の活動を抑制し、不活化します。流行しているノロウイルスやA型インフルエンザにも効果が期待できます。
鮮度保持・抗酸化
白金(プラチナ)は、触媒作用により、活性酸素を除去する効果があります。更に既存の抗酸化素材と違い、全ての活性酸素に効果が絶大にあり、体内にある限り活性酸素を除去します。化粧品やサプリメントとして使われています。
安全性
経口投与毒性試験、皮膚貼布試験、皮膚1次刺激性試験、皮膚感作性試験、細胞毒性試験、復帰突然変異試験の毒性試験において安全性を確認済み。特にプラチナは、国から食品添加物に認定されている点も優れています。

プラチナナノ(Pt nano)溶液の効果及び特徴
SEK赤ラベル認定
※本認定は更新をしておりませんので、商品企画や宣伝にはご使用いただけません。
SEK赤マーク(制菌加工・特定用途)
認定番号58SA06取得
繊維評価技術協議会が認証するSEK赤マークは繊維製品にPTnano溶液を含浸させ乾燥させた後、80℃の温度で50回洗濯しても抗菌効果がある厳しい基準をクリアしていないと取得できません。
試験の検体となる、黄色ブドウ球菌・肺炎桿菌・MRSAの抗菌試験に合格。
既存技術等との相違点
| PTnano溶液 | 他社製 |
| 常温で簡単に製造できる | 白金ナノ加工は高価で難しい |
| バインダー等の工夫が不必要 | 固着させるためにバインダー等の工夫が必要 |
| ナノ分散構造で少量化、機能化が可能 | 効果を得るために一定量が必要 |
安全性
検査機関: 生活科学研究所 ※繊維評価技術協議会指定検査機関
・経口投与毒性試験
14日間の検察結果2000㎎/kg以上と判定
・ 皮膚1次刺激性試験
非刺激性であると判定
・皮膚感作性試験
皮膚感作性は認められない
・細胞毒性試験
細胞増殖抑制は認められない
・ 皮膚貼布試験
被験者全員(20名)に刺激性は認められない
・復帰突然変異試験
変異原性は陰性
